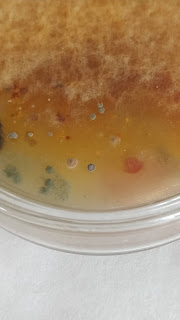

luns, 28 de decembro de 2020
luns, 21 de decembro de 2020
CLUB DE CIENCIA AGUIAR. NOVEMBRO 2020. "UN MUNDO INVISIBLE"
DEPARTAMENTO DE BIOLOXÍA E XEOLOXÍA: Celtia González, Laura Álvarez e Chus Santamariña.
Cultivos realizados con mans limpas e sucias. Cada placa Petri divida en tres segmentos, un para cultivo de mans limpas (L), outro de mans sucias (S) e outro como control (C).
HORA DE LER
11ª Semana
[5ª Sesión]
**********
SUPUESTOLo que sí asombró al personal del neuropsiquiátrico fue escuchar en los noticieros, en la mañana del 25, que esa noche ningún niño del planeta había recibido su regalo.
venres, 18 de decembro de 2020
CALENDARIO SOLIDARIO AGUIAR 2021
CALENDARIO AGUIAR 2021
martes, 15 de decembro de 2020
LECCIÓN DE ANATOMÍA
O alumnado de Anatomía de 1º de Bach atreveuse coa disección dunha pata de polo nas súas casas, levando así á práctica a teoría vista na aula.
Aquí tedes o vídeo feito por Lourdes Nieto Mantiñán, no que se identifican perfectamente os diferentes tecidos que compoñen a patiña do polo.
Noraboa polo traballo feito a toda a clase!
domingo, 13 de decembro de 2020
HORA DE LER
10ª Semana
[4ª Sesión]
Cantas veces ler permite habitar outro espazo, tanto ou máis real que o das nosas vidas.
Pode ser que algún lector se adentre, grazas a estes relatos, nos mundos debuxados por Ray Bradbury e Manuel Rivas.
xoves, 10 de decembro de 2020
mércores, 9 de decembro de 2020
CLUB DE LECTURA DE ADULTOS BIBLOS AGUIAR
martes, 8 de decembro de 2020
HORA DE LER
9ª Semana
[3ª Sesión]
morriña: substantivo feminino Sentimento e estado de ánimo melancólico e depresivo, en particular o causado pola nostalxia da terra.
Sentía moita morriña no estranxeiro. Nos días de chuvia éntrame a morriña
Nos días de chuvia éntranos a morriña de emular ao neniño que debuxa Jimmy Liao tumbado entre follas de pradairo, carballo e castiñeiro.
Aínda tan lonxe desa luminosidade e desas cores, chéganos o pulo para comezar a ler a Berta Dávila e Dylan Thomas.
mércores, 2 de decembro de 2020
CALENDARIO AGUIAR 2021
A Biblioteca Sebastián Buedo Jiménez organiza un concurso artístico-literario.
Todos os alumnos que desexen participar farán unha ilustración relativa a un dos doce meses do ano.
A ilustración levará un pé de imaxe cun pequeno texto en galego referido ao mes elexido.
A disposición da páxina será horizontal.
Os traballos orixinais serán entregados aos profesores de Educación Plástica e Visual ou na Secretaría antes do mércores 16 de decembro.
Os doce mellores traballos elexidos servirán para compoñer un Calendario Aguiar para o próximo ano 2021.
martes, 1 de decembro de 2020
luns, 30 de novembro de 2020
HORA DE LER
HORA DE LER
Atopar o noso verdadeiro rostro cando estamos a ler.
Por exemplo, un conto de Cid Cabido ou de Jaume Cabré.
venres, 27 de novembro de 2020
xoves, 26 de novembro de 2020
mércores, 25 de novembro de 2020
25 DE NOVEMBRO, DÍA INTERNACIONAL DA ELIMINACIÓN DA VIOLENCIA CONTRA A MULLER
Haberá algún día no que non sexa urxentemente imprescindible vestir de negro-loito para reinvindicar, con rabia, a igualdade entre persoas, para berrar, con ira, en contra da violencia machista.
Tamén pronto chegará o día no que as persoas poidan mirarse aos ollos sen medos, falar sen máscaras, tocarse as mans, prestarse un lapis ou unhas moedas para mercar na cafetería un bocata sen ter que respectar unha cola en ringleira: un mundo sen a distancia interposta dun metro e medio...
Mentras tanto que potente a icónica imaxe que tomou Chus Santamariña aos seus titorandos.
Oxalá axiña sexa historia.
O IES Francisco Aguiar mobilízase un ano máis no 25 de novembro, Día internacional da Eliminación da Violencia contra as mulleres.
Como centro, queremos mostrar o noso profundo rexeitamento de todas as formas de violencia que sufren as mulleres e vestindo de negro chamamos a afrontar este gravísimo problema que temos como sociedade.
Así mesmo, queremos agradecer publicamente ao Concello de Betanzos o lote de libros con temática igualitaria adquirido para a nosa biblioteca.
luns, 23 de novembro de 2020
HORA DE LER
venres, 20 de novembro de 2020
PANDEMIAS, Tomek Zarnecki & Gosia Kulik
TOMEK ŻARNECKI & GOSIA KULIK, Pandemias, Thule Ediciones, Barcelona, 96 páxinas.
***
Este é un libro ilustrado aproxima ao lector a historia das pandemias que asolaron á humanidade: un libro informativo moi necesario para comprender o noso pasado e, polo tanto, para poder albiscar o noso futuro.
mércores, 18 de novembro de 2020
BETANZOS EN NEGRO
luns, 16 de novembro de 2020
HORA DE LER
HORA DE LER
6ª Semana [6ª sesión]
Paisaxe outonal. Unha folla de pradairo para lembrar onde temos que recomezar a lectura de obras como as de as obras de Paula Sánchez Regueiro, Violeta Silva Sánchez, Amaia Tomé Tomé, Raquel Vázquez ou Óscar García Ramos.
luns, 9 de novembro de 2020
HORA DE LER
5ª Semana [5ª sesión]
Ler para escribir. Escribir para volver a ler.
Esta semana deixamos nas mans dos lectores os relatos de Irène Némirovsky e Mariña Garcia Iglesias, Hugo Vicente Cabanas e Paula Fernández Vidal, alumnos de 1º de Bacahrelato.
martes, 3 de novembro de 2020
HORA DE LER
HORA DE LER
4ª SEMANA [4ª SESIÓN]
Compartimos esta semana as seguintes suxestións de lectura: as historias da muller esquelete e a morte amante o Xinete Descabezado, unha selección de micros de terror.
sábado, 24 de outubro de 2020
HORA DE LER
O pasado sábado 24 celebramos o Día da Biblioteca.
Hoxe, tendo entre as mans os relatos de Ana María Matute ou Stephen Dixon, podemos terStephen Dixon, podemos recordar as palabras da literata arxentina Jeannette L. Clariond: «Somos cando comezamos a leer. Existimos cando aprendemos a lernos».
Lendo somos libres, somos libro.
DÍA DA BIBLIOTECA
mércores, 21 de outubro de 2020
CONCURSO DE [MICRO] RELATOS DE TERROR
luns, 19 de outubro de 2020
HORA DE LER
HORA DE LER
2ª SEMANA [2ª SESIÓN]
Cavilando,
pode ser, sobre as mesmas sensacións que a lectora pintada por Shelley
Thayer Layton, repensamos esas palabras lidas nos textos de Almudena Grandes ou Miguel-Anxo Murado, para volver aos misterios que tornan en algo tan real toda ficción.
martes, 13 de outubro de 2020
O ALUMNADO DE 1º DE ESO CONTRA A COVID
HORA DE LER
HORA DE LER
1ª SEMANA [1ª SESIÓN]
Como ven sendo costume desde fai tantos anos xa, retornamos a ler, adicando os quince primeiros minutos da primeira sesión. Cada lectora ou lector pode traer da súa casa un libro, unha revista ou novela gráfica...
Para os que esquecezan traerlos (ou para os que acepten o reto) quedan dúas suxestións de lectura: unha selección de poemas de Wislawa Szymborska e outra pequena antoloxía de Louise Glück, as dúas últimas poetas merecedoras do Premio Nobel de Literatura (Symborska en 1996, Glück no 2020): poesía transparente para tempos de pandemia e mascarillas.
Ilustración: Fernando Vicente
xoves, 8 de outubro de 2020
HORA DE LER
mércores, 7 de outubro de 2020
NA ESTRADA, Jack Kerouac
venres, 2 de outubro de 2020
PROTOCOLO COVID-19 DO IES FRANCISCO AGUIAR
martes, 25 de agosto de 2020
luns, 24 de agosto de 2020
ORACIÓN EN EL HUERTO, Juan Gallego Benot
[PC GAL ora]
Amor, pregúntame esta tarde. Sabré aprehender
tus palabras con mi alma de carne y de miseria;
amor, desgráname en tus labios con los párpados;
amor, derrama el cántaro en el rincón tranquilo,
viértete en la hondura de mi abierto mimbre:
el agua que te ofrezco está desnuda en mi garganta.